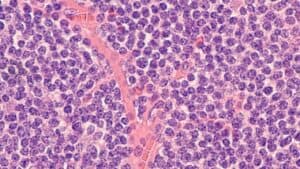

Área técnica da agência estima que a implementação do procedimento custará, em média, R$ 3…
Linfoma do manto: acalabrutinibe se torna primeira linha terapêutica
A Agência Nacional de Vigilância Sanitária (Anvisa) aprovou, em junho, a indicação do acalabrutinibe combinado com bendamustina e rituximabe como primeira linha terapêutica para tratamento de linfoma das células do manto (LCM). O medicamento é o primeiro inibidor da tirosina quinase de Bruton (iBTK) aprovado na terapia de primeira linha do LCM para pacientes não tratados anteriormente e inelegíveis ao transplante de medula óssea.
O Linfoma do Manto é um subtipo raro de linfoma não-Hodgkin de células B. Para se propagar, as células B precisam de uma enzina de tirosina quinase de Bruton. Assim, o acalabrutinibe bloqueia a ação dessa enzima e, consequentemente, as células B com características cancerígenas não conseguem mais crescer e sobreviver.
O inibidor foi aprovado com base na fase III do estudo ECHO, que analisou a eficácia da combinação dos medicamentos em pacientes com LCM que ainda não tinham sido tratados e eram inelegíveis ao transplante de medula óssea (TMO).

